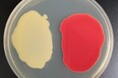
スマートセルによる「リコピン」の大量生産技術を開発しました

プレスリリース一覧
- 表示切り替え

地域の健康を応援!きたひろげんき体操がフレップとコラボしリニューアル!
北広島市役所
韓国スーパーHANAMARTが品川にオープン!
NAO HOLDINGS合同会社
40℃を超える猛暑から商品を守る|群馬県伊勢崎市に600坪の定温倉庫
株式会社長岡運送
つながっていく中島重久堂の企業風土
株式会社中島重久堂
京都・城陽に新イタリアン誕生 ── 人気2店舗を統合した「Osteria Lo Stuzzichino」3/3オープン
株式会社simple plan
【Amazon第1位獲得】代表・坪田康佑が執筆・監修の『看護×生成AI 実践ガイド』が大反響!
一般社団法人日本男性看護師會
三井ミーハナイト・メタルグループの従業員に対して、「福島県プレコンセプションケア企業向け出前講座」を開...
株式会社ファミワン
純水洗車場「D-Wash 日進香久山」が 2026 年 3 月オープン!
大和ハウス工業株式会社
『ラブライブ!スーパースター!!』の描き下ろし スーパースター!!ver. トレーディングアクリルマグネットなど...
株式会社arma bianca
かさばるACアダプタをUSB-C電源で代替する「VFLEX」、国内での一般発売開始
株式会社IntoFree
「井上芳雄ミュージカルアワー『芳雄のミュー』」オリジナルグッズ販売決定!
株式会社WOWOW
【クラファン限定】日本一のバーテンダーが監修する至高の空間を独占。3/1オープン『BAR 大宮ウイスキーサロ...
株式会社ロイヤルマイル
【TSUKUMO】G-GEAR、「インテル Core Ultra 7 270K Plus」を搭載したゲーミングPCを3月26日に発売予定
株式会社 ヤマダホールディングス
【設立1年で参画エンジニア30名突破】日本AIセンター株式会社、生成AIを駆使する「AI活用型SES」で業界最高水...
日本AIセンター株式会社
韓国SNSで話題の『ドバイチョコ餅』行列のできるFRUITS SAND THREE / Age.3がザク×もちの新食感スイーツを発売
株式会社ANCHOR
赤ちゃんボランティアの特養「銀杏庵 穴生俱楽部」が年間大賞|第9回4USELECTION介護施設AWARD2025
合同会社4U
社会福祉法人ちとせ交友会、2026年4月1日より新たに「広尾ちとせ保育園」(渋谷区)を運営開始
社会福祉法人ちとせ交友会
スマートセルによる「リコピン」の大量生産技術を開発しました
NEDO
【とろけるチョコ&もちもち新食感!】「ねこねこ」より“チョコ×餅”を楽しめる『ねこねこ食パン チョコもっち...
株式会社オールハーツ・カンパニー
【3/16(月)開始】日本棋院公式アプリ「囲碁シル」、AI囲碁ロボット「SenseRobot」とコラボキャンペーンを開催...
株式会社UNBALANCE
ケアエンタメソリューションアプリ第一弾「BrainTQ」国内正式リリース
AXテックケア株式会社
国際女性デーにIMARUさんとともに“女性の次の一歩を考える”トークイベントを開催。
ロクシタンジャポン株式会社
INOV8から “横浜DeNAベイスターズ” デザインのアウトドアサンダル登場
デサントジャパン株式会社
【名古屋・歓送迎会】最高の門出を焼肉で!「焼肉ジャック 名古屋駅前店」が8名以上の予約で主役1名無料キャ...
株式会社DIC
「UEFA女子チャンピオンズリーグ」を、今シーズンから2029-30シーズンまで新たにWOWOWで放送・配信決定!
株式会社WOWOW
PW Consulting最新レポート:世界のペットケージドライヤー市場、2023–2028年に年平均8.5%成長へ
PW Consulting Limited
「UEFAチャンピオンズリーグ」を、今シーズンに引き続き 2030-31シーズンまでの5シーズンWOWOWで独占生放送・...
株式会社WOWOW
PW Consulting、世界のモジュラーエレベーター市場洞察—2029年に市場規模317.1百万ドルへ拡大
PW Consulting Limited
【TAC宅建士講座】3/18(水)19:00~宅建学習経験者向けオンライン説明会の第2弾の開催決定!
TAC株式会社
【子どもにも安心】燃えにくい、の先へ。安心と機能性を追求◎薄型・軽量の「半固体モバイルバッテリー」を4月...
株式会社バッファロー
メディア関係者の方のみご覧頂けます
両備ホールディングス株式会社
『葬送のフリーレン』のトレーディング ちびキャラ 社交界ver. アクリルスタンドなどの受注を開始!!アニメ...
株式会社arma bianca
熱を解き放ち、眠りを変える─放熱テクノロジー搭載「ZUKANフトン」発売
フランスベッドホールディングス株式会社
新作PvPvE 『NAKWON: LAST PARADISE』本日よりクローズド・アルファテストを開始!
株式会社ネクソン
『凛と生きるための禅メンタル』、続々重版で8刷・3万部突破! 反応しない・比べない・自分への誇りを失わ...
株式会社飛鳥新社
⻄鉄×LINE ヤフーコミュニケーションズ、DX 協定 5 周年 LINE FRIENDS の完全描き下ろしラッピング電⾞が福岡...
にしてつグループ
Fracton Veturesに業界を代表する3名のアドバイザーが就任
Fracton Ventures株式会社
エクセルイン名古屋熱田で「熱田神宮」音声ガイドサービス開始|フロントもリニューアルし物語ある空間へ
株式会社on the trip
ユーザックシステム、「健康経営優良法人2026(大規模法人部門)」に認定
ユーザックシステム株式会社
